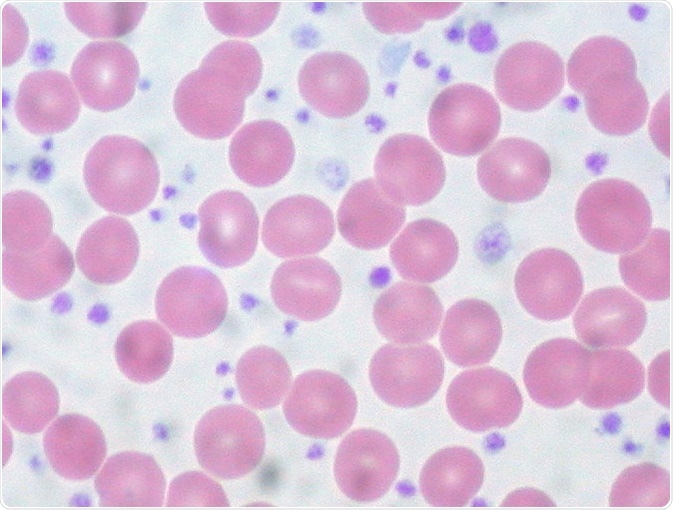
'Essential Thrombocythemia, Peripheral Blood

Essential thrombocythemia (ET) is a rare condition affecting the bone marrow, resulting in an overproduction of platelets. It usually affects those over the age of 50, progresses slowly, and can be asymptomatic.
Skip to
What Causes Essential Thrombocythemia?
As ET is a condition affecting the bone marrow, it is important to understand the function of bone marrow, and how complications can lead to essential thrombocythemia.
Stem cells, which are blood cells in their earliest developmental phase, are produced in bone marrow. The three main types of blood cells (white blood cells, red blood cells, and platelets) are all produced in their millions every day from these stem cells. In essential thrombocythemia, too many platelets are produced, which are blood cells responsible for helping blood to clot.
Myeloproliferative neoplasms can cause the overproduction of platelets. Mutations are often found in the JAK2, CALR, or MPL genes. Statistics show that approximately 60 percent of people living with ET have mutations in the JAK2 gene, 30 percent have mutations in the CALR gene, and five percent have a fault in the MPL gene.
"Essential Thrombocythemia, Peripheral Blood" by euthman is licensed under CC BY 2.0
The Role of JAK2, CALR, and MPL Genes in Bone Marrow
Growth factors, which are substances that transmit signals to stem cells in order to produce blood cells when counts of certain types of cell are low, transmit signals to the JAK2 and MPL genes. Faults in these genes allow them to produce platelets without instruction from a growth factor, meaning platelets are produced even if healthy amounts of platelets are already present in the blood.
Faults can occur in the JAK2 and MPL genes after exposure to dangerous chemicals, but faults are typically due to errors made when the cell divides.
Although the CALR gene has been implicated in ET, the gene itself is not yet fully understood outside of its ability to provide instruction to make a multifunctional protein calreticulin, which is thought to play a part in controlling gene activity, cell growth, migration, adhesion, and proliferation through calcium regulation among other mechanisms.
Symptoms of Essential Thrombocythemia
Typically, essential thrombocythemia does not present any symptoms. However, older people and those with significantly high platelet counts may present symptoms. These symptoms can include:
- Persistent headaches
- Vision problems
- Tinnitus
- Dizziness
- Bruising or bleeding easily
- Heavy periods in women
- Erythromelalgia (pain and redness in the hands, feet, arms, legs, ears, and face)
- Blue, cold fingers and toes.
Diagnosis of Essential Thrombocythemia
Essential thrombocythemia can sometimes be detected after a blood test is taken to diagnose other conditions, but there are particular blood tests available that specifically test for the presence of essential thrombocythemia if a patient is presenting a set of symptoms associated with ET. More specifically, these ET-specific blood tests aim to identify changes in certain genes that can lead to ET. These tests extract DNA from the blood sample and test for genetic faults in the JAK2, CALR, and MPL genes.
A full blood count test can also be carried out, which will detect whether the blood platelet count is higher than normal, thus indicating a possible case of essential thrombocythemia.
The bone marrow itself can also be tested to diagnose ET. A sample of bone marrow cells, called a bone marrow biopsy, is taken from the back or hip bone and analyzed to rule out alternative conditions affecting the bone marrow, such as myelofibrosis.
Risk Factors for Essential Thrombocythemia
Essential thrombocythemia is not a condition you are born with. Because it results from a somatic mutation (not a mutation to sex cells), it cannot be passed down to children. Along with genetic faults, there are a number of other suspected risk factors associated with essential thrombocythemia, including increasing age.
There is no difference in ET incidence between males and females.
Those diagnosed with essential thrombocythemia are also at a higher risk of developing thrombosis, commonly known as blood clots. This includes deep vein thrombosis, in which clots form in the veins of the legs. Thrombosis can occur in the brain, eyes, abdomen, and heart, and is a serious condition.
More worrisome than the symptoms of ET is the risk of progression to myelofibrosis or acute myeloid leukemia. Less than five percent of people with ET will progress to myelofibrosis, in which the bone marrow become scarred and its ability to produce cells inhibited. In acute myeloid leukemia, not enough red blood cells, platelets, and certain types of white blood cells are produced.
A high platelet count does not necessarily mean a person has essential thrombocythemia. High platelet counts can also be caused by:
- Iron deficiencies
- Unusual bleeding
- Infections
- Arthritis
- Certain types of cancer
- Spleen dysfunction
- Other bone marrow diseases such as polycythemia vera, primary myelofibrosis, and chronic myeloid leukemia.
Treatments for Essential Thrombocythemia
Chemotherapy can be used to reduce the amount of platelets. Other treatments include:
- Certain painkillers, which can prevent blood clots
- A range of chemotherapy treatments that inhibit cell proliferation and platelet maturation
- Radioactive phosphorus (32P).
Summary
Many people do not know they have essential thrombocythemia until they have a blood test for another problem. It is often caused by genetic mutations that can occur at any stage of a person’s life, however ET is more common in older people. Chemotherapy and certain painkillers can be used to manage the condition, which is typically asymptomatic, and does not tend to shorten lifespans if it is carefully treated.
Further Reading
Last Updated: May 6, 2019